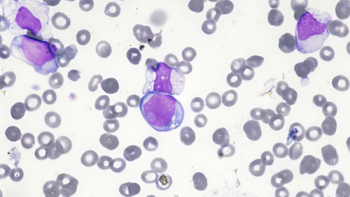

Treatment is the first approved for eyelid disease.

Treatment is the first approved for eyelid disease.

Collaboration aims to treat hypertension in patients with high cardiovascular risk.

Layoff comes amid preparations for Leqembi launch.

Navigating the challenging landscape of pharmaceutical naming—where a name must meet regulatory approval, clear trademark hurdles, and capture market attention all at once.

Collaboration intended to enable faster market delivery time for life-threatening disease medications.
Approval of Vanflyta comes nearly four years after initial rejection.

Move likely to be completed by early next year.

Collaboration aims to help pharmaceuticals drive efficiencies and business value.

Research to focus on multiple immunological and inflammatory indications.

New organization to focus on advancing genetic medicines.

Collaboration to focus on the treatment and prevention of genomic diseases.

$100 million investment to address pharma’s strategic areas of interest.

Company anticipates launch of a standalone organization.

Join us as Mohit Manrao, SVP and head of US oncology at AstraZeneca, shares his patient-centered approach to transforming cancer care, bridging the gap between innovative science and tangible patient outcomes across all populations on a global scale.

Company aims to utilize technology for efficient Parkinson’s treatment.

An insightful discussion about how Meta's newest social media platform, Threads, is quickly adding another facet to the digital landscape for pharma marketers.

Pharma giant to serve as Team USA’s partner in prescription medicine and health equity.

Agency claims union would threaten a monopoly on programmatic advertising space.

Obtained assets expected to expand capabilities in RNA-based therapeutics.

Demand comes among antitrust agency’s recent denial of Amgen’s Horizon buyout.

Companies aim to discover novel molecules that promote precise delivery of nucleic acid.

Merger aims to advance RNA editing programs.

Cloud-based solution updates pharma regulatory and commercial teams ability to review text and content.

Organizations plan to accelerate development of models for biology and chemistry.

Funding to support development of company’s oral p300/CBP inhibitor.